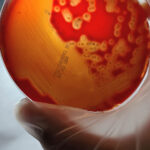

Tatil Sonrası Uyku Nasıl Rutine Dönülür?

Tatil döneminde uyku düzeni bozulan çocuğunuzun okula dönüş döneminde, yeniden sağlıklı bir uyku rutinine döndürmek oldukça önemlidir. Uyku rutini çocuğunuzun, hem fiziksel hem de zihinsel sağlığı için kritik bir rol oynar.
İşte size tatil sonrası uyku rutini oluşturmak için öneriler:
Uyku rutinine yavaş yavaş dönmeye çalışın.
Tatil bitmeden birkaç gün önce, çocuğun uyku saatini yavaş yavaş okul dönemindeki saatine çekmeye çalışın. Bu size ani değişiklikler yerine yumuşak bir geçiş yapmanızı sağlar.
Uyku öncesi rahatlatıcı aktiviteler yapın.
Uyku saatine yaklaşırken kitap okumak, sıcak bir banyo yapmak gibi rahatlatıcı aktiviteler çocuğun gevşemesine yardımcı olur ve uykuya hazırlık sürecini kolaylaştırır.
Dijital ekran süresini sınırlayın.
Özellikle akşam saatlerinde telefon, tablet ve televizyon gibi ekranlardan çocuğunuzu uzak tutun. Ekrandan yansıyan mavi ışık, melatonin üretimini azaltarak uykuya dalmayı zorlaştırabilir.
Çocuğun uyku ortamının düzenleyin.
Çocuğun uykuya dalacağı ve uyuyacağı ortam karanlık, sessiz ve serin olmalıdır. Uyumadan önce yatak odasının düzenli ve dikkatini dağıtabilecek unsurlardan arındırılmış olması önemlidir.
Her gün aynı saatte yatıp kalkmasını sağlayın.
Çocuğun biyolojik saatin düzenlenmesi için her gün aynı saatte yatıp kalkması son derece önemlidir. Bu uyku rutini oluşturmanıza yardımcı olurken bir yandan da uyku kalitesini artırır.
Uyku rutini oluşturmak akademik başarıyı arttırır.
Uyku ile ilgili yapılan araştırmalarda, düzenli bir uykunun çocukların genel gelişimi üzerinde olumlu etkileri olduğunu gösterilmiştir. Sağlıklı ve yeterli uyku sürelerinin, çocukların akademik başarıları, duygusal durumları ve davranışları üzerinde belirgin olumlu etkileri olduğu hatta davranış sorunlarını azalttığı gözlemlenmiştir. Bu nedenle çocukların okul dönemine dönüş döneminde uyku rutinlerine dikkat etmek, onların sağlıklı şekilde okula adapte olmalarına yardımcı olacaktır.